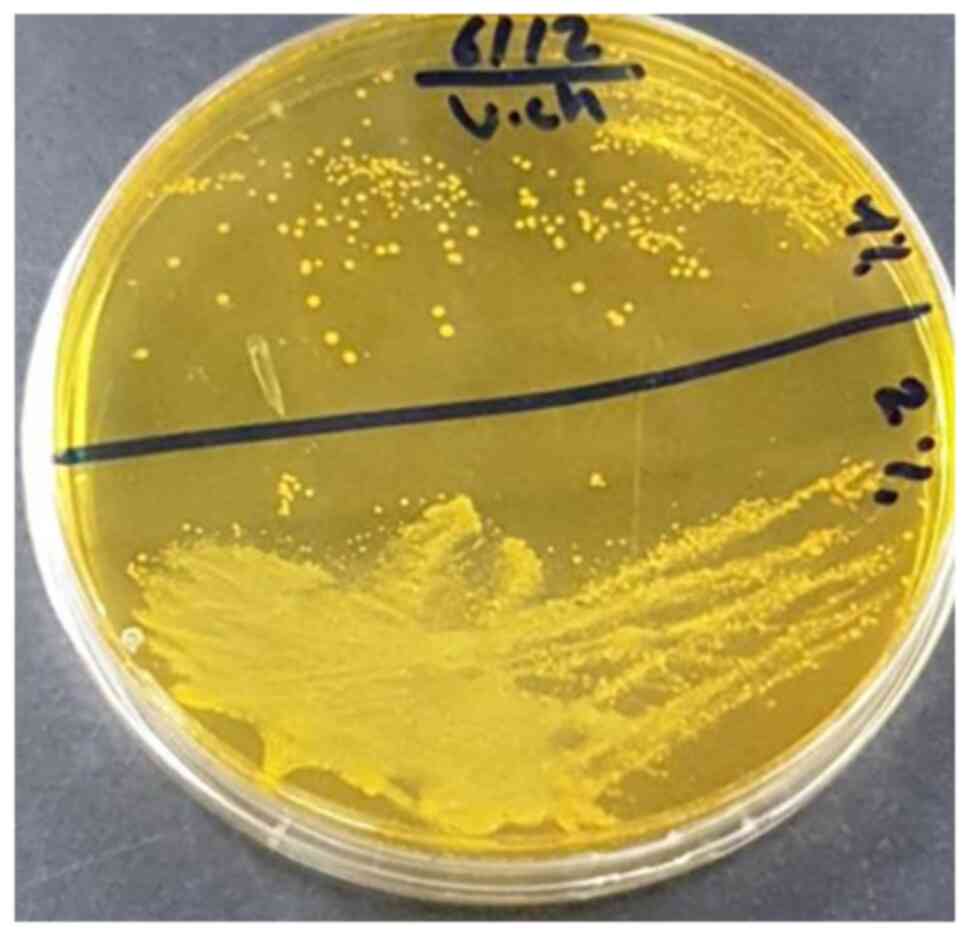
Colonies of Vibrio cholerae
isolated from water samples growing on thiosulfate-citrate-bile
salt (TCBS) agar.
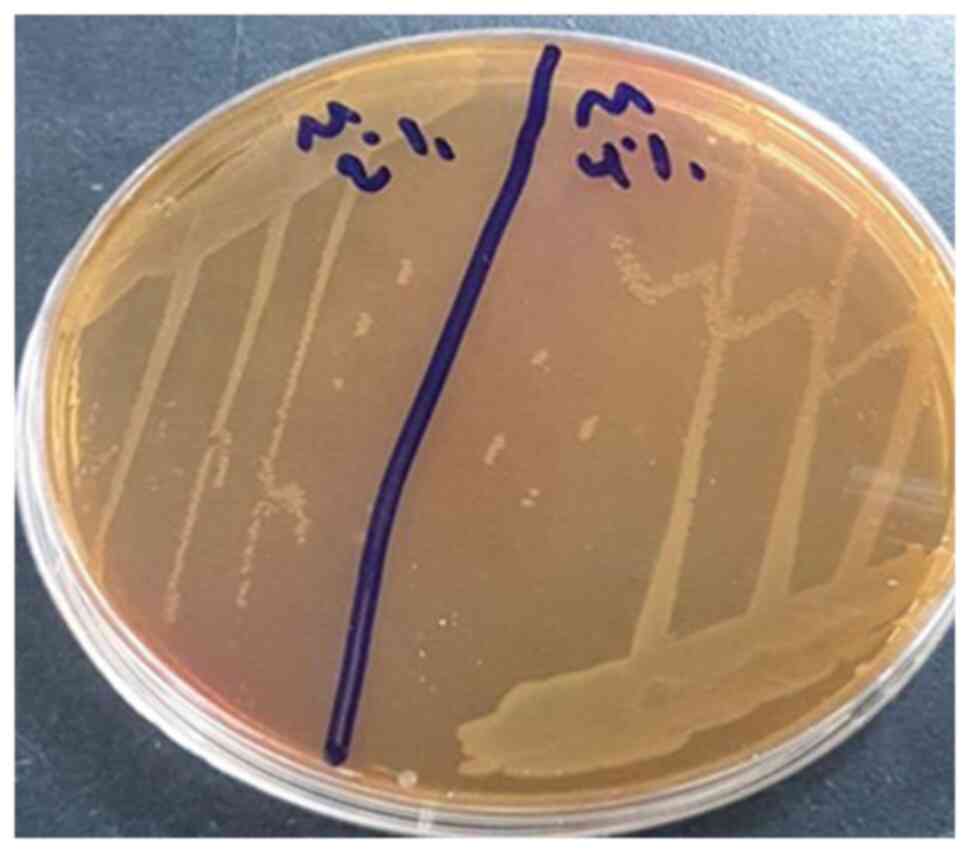
Colonies of Morganella
morganii isolated from water samples growing on MacConkey
agar.
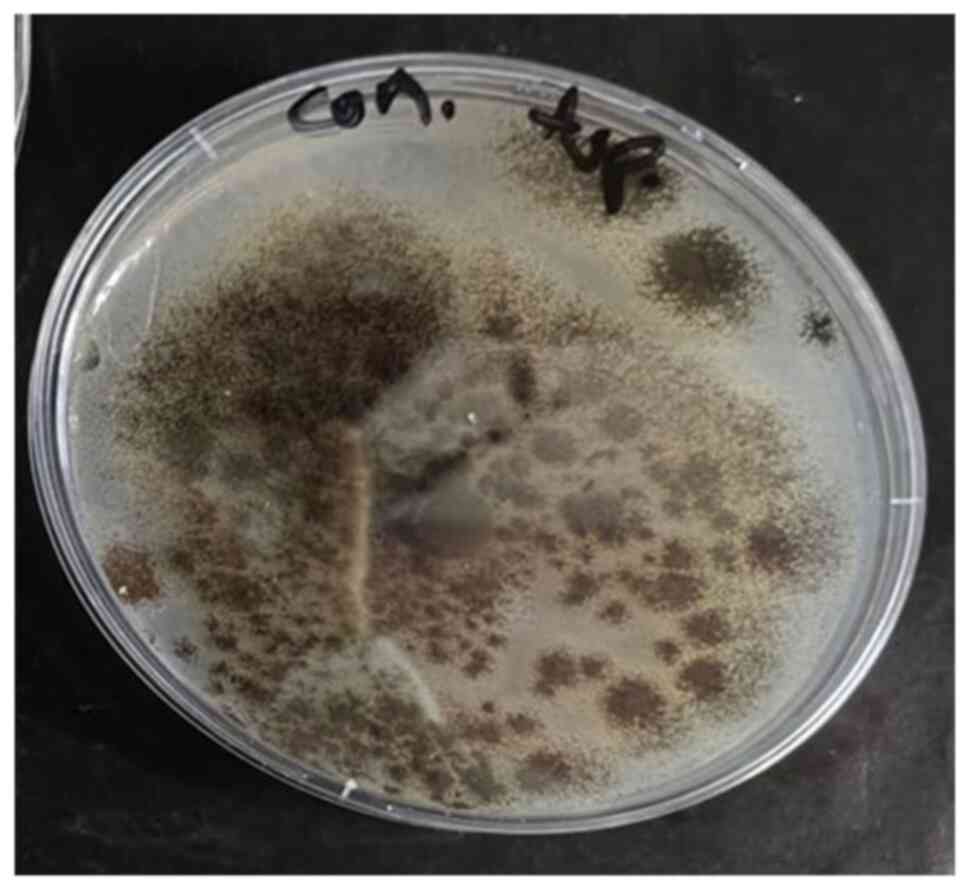
Colony of Aspergillus niger
isolated from water samples growing on potato dextrose agar
(PDA).
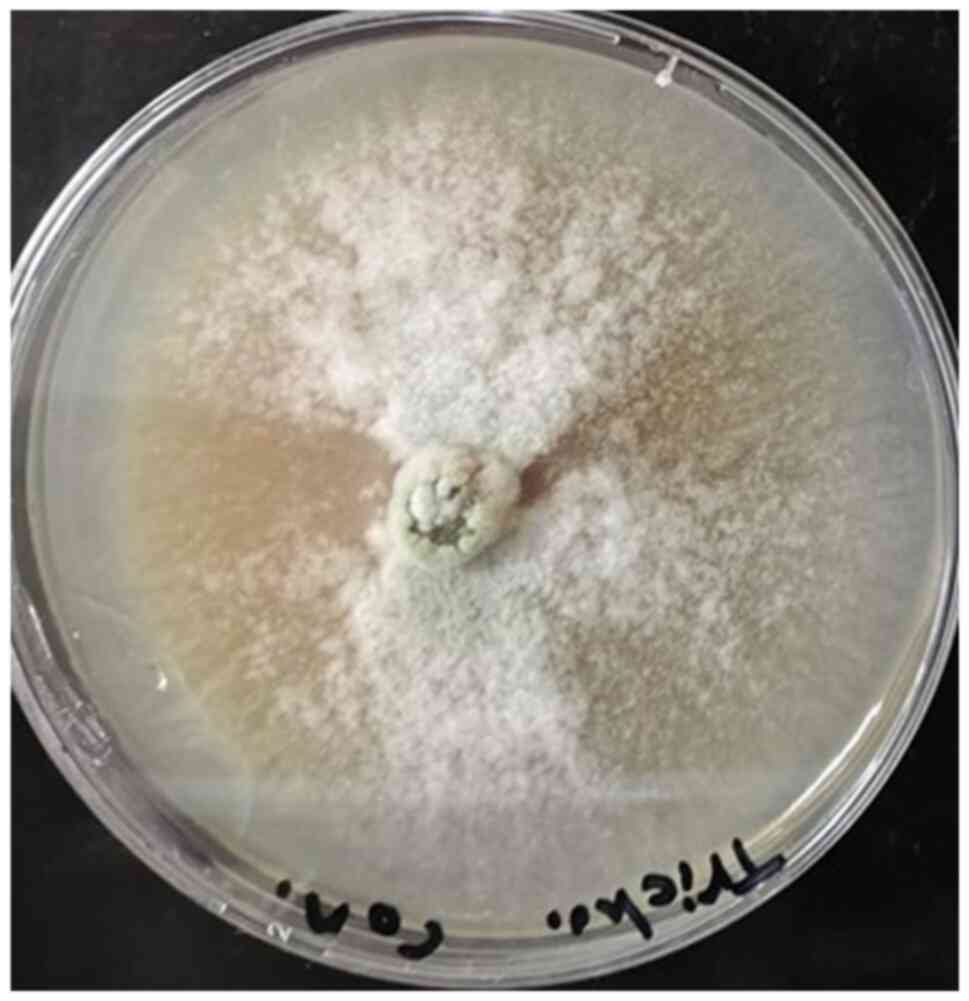
Colony of Trichoderma
harzianum isolated from water samples growing on potato
dextrose agar (PDA).

|
1
|
Cavicchioli R, Ripple WJ, Timmis KN, Azam
F, Bakken LR, Baylis M, Behrenfeld MJ, Boetius A, Boyd PW, Classen
AT, et al: 2019: Scientists' warning to humanity: microorganisms
and climate change. Nat Rev Microbiol. 17:569–586. 2019.PubMed/NCBI View Article : Google Scholar
|
|
2
|
Mora C, McKenzie T, Gaw IM, Dean JM, von
Hammerstein H, Knudson TA, Setter RO, Smith CZ, Webster KM, Patz JA
and Franklin EC: Over half of known human pathogenic diseases can
be aggravated by climate change. Nat Clim Chang. 12:869–875.
2022.PubMed/NCBI View Article : Google Scholar
|
|
3
|
Gross M: Permafrost thaw releases
problems. Curr Biol. 29:R39–R41. 2019.
|
|
4
|
Guzman Herrador BR, De Blasio BF,
MacDonald E, Nichols G, Sudre B, Vold L, Semenza JC and Nygård K:
Analytical studies assessing the association between extreme
precipitation or temperature and drinking water-related waterborne
infections: A review. Environ Health. 14(29)2015.PubMed/NCBI View Article : Google Scholar
|
|
5
|
Sobral MFF, Duarte GB, da Penha Sobral
AIG, Marinho MLM and de Souza Melo A: Association between climate
variables and global transmission oF SARS-CoV-2. Sci Total Environ.
729(138997)2020.PubMed/NCBI View Article : Google Scholar
|
|
6
|
Chua PLC, Huber V, Ng CFS, Seposo XT,
Madaniyazi L, Hales S, Woodward A and Hashizume M: Global
projections of temperature-attributable mortality due to enteric
infections: a modelling study. Lancet Planet Health. 5:e436–e445.
2021.PubMed/NCBI View Article : Google Scholar
|
|
7
|
Magnano San Lio R, Favara G, Maugeri A,
Barchitta M and Agodi A: how antimicrobial resistance is linked to
climate change: An global challenges overview of two intertwined.
Int J Environ Res Public Health. 20(1681)2023.PubMed/NCBI View Article : Google Scholar
|
|
8
|
Sampaio A, Silva V, Poeta P and
Aonofriesei F: Vibrio spp.: Life strategies, ecology, and risks in
a changing environment. Diversity. 14(97)2022.
|
|
9
|
Li H, Chen Z, Ning Q, Zong F and Wang H:
Isolation and identification of morganella morganii from rhesus
monkey (Macaca mulatta) in China. Vet Sci. 11(223)2024.PubMed/NCBI View Article : Google Scholar
|
|
10
|
Liu H, Zhu J, Hu Q and Rao X: Morganella
morganii, a non-negligent opportunistic pathogen. Int J Infect Dis.
50:10–17. 2016.PubMed/NCBI View Article : Google Scholar
|
|
11
|
Wheeler KA, Hurdman BF and Pitt JI:
Influence of pH on the growth of some toxigenic species of
Aspergillus, Penicillium and Fusarium. Int J Food Microbiol.
12:141–149. 1991.PubMed/NCBI View Article : Google Scholar
|
|
12
|
Rhouma A, Salem IB, M'hamdi M and
Boughalleb-M'Hamdi N: Relationship study among soils
physico-chemical properties and Monosporascus cannonballus
ascospores densities for cucurbit fields in Tunisia. Eur J Plant
Pathol. 153:65–78. 2019.
|
|
13
|
Abdel-Hadi A and Magan N: Influence of
physiological factors on growth, sporulation and ochratoxin A/B
production of the new Aspergillus ochraceus grouping. World
Mycotoxin J. 2:429–434. 2009.
|
|
14
|
Cao C, Li R, Wan Z, Liu W, Wang X, Qiao J,
Wang D, Bulmer G and Calderone R: The effects of temperature, pH,
and salinity on the growth and dimorphism of Penicillium marneffei.
Med Mycol. 45:401–407. 2007.PubMed/NCBI View Article : Google Scholar
|
|
15
|
Abubakar A, Suberu HA, Bello IM,
Abdulkadir R, Daudu OA and Lateef AA: Effect of pH on mycelial
growth and sporulation of Aspergillus parasiticus. J Plant Sci.
1:64–67. 2013.
|
|
16
|
Druzhinina IS, Kopchinskiy AG, Komoń M,
Bissett J, Szakacs G and Kubicek CP: An oligonucleotide barcode for
species identification in Trichoderma and Hypocrea. Fungal Genet
Biol. 42:813–828. 2005.PubMed/NCBI View Article : Google Scholar
|
|
17
|
Jones EG, Suetrong S, Sakayaroj J, Bahkali
AH, Abdel-Wahab MA, Boekhout T and Pang KL: Classification of
marine ascomycota, basidiomycota, blastocladiomycota and
chytridiomycota. In: Fungal Diversity. Vol 73. Springer, New York,
NY, pp1-72, 2015.
|
|
18
|
Daboul J, Weghorst L, DeAngelis C, Plecha
SC, Saul-McBeth J and Matson JS: Characterization of Vibrio
cholerae isolates from freshwater sources in northwest Ohio. PLoS
One. 15(e0238438)2020.PubMed/NCBI View Article : Google Scholar
|
|
19
|
Pincus DH: Microbial identification using
the bioMérieux Vitek® 2 system. In: Encyclopedia of Rapid
Microbiological Methods. Parenteral Drug Association, Bethesda, MD,
pp1-32, 2006.
|
|
20
|
Silva APRD, Longhi DA, Dalcanton F and
Aragão GMFD: Modelling the growth of lactic acid bacteria at
different temperatures. Braz arch biol Technol.
61(e18160159)2018.
|
|
21
|
CLSI: Methods for Antimicrobial Dilution
and Disk Susceptibility Testing of Infrequently Isolated or
Fastidious Bacteria. 3rd edition. Clinical and Laboratory Standards
Institute, Wayne, PA, 2015.
|
|
22
|
Romero MC, Hammer E, Hanschke R, Arambarri
AM and Schauer F: Biotransformation of biphenyl by filamentous
fungus Talaromyces helicus. World J Microbiol Biotechnol.
21:101–106. 2005.
|
|
23
|
Webster J (ed): Introduction to Fungi.
Cambridge University Press, New York, NY, p669, 1980.
|
|
24
|
Moor-Landecker E: Fundamentals of Fungi.
Prentice-Hall India, New Delhi, pp265-277, 1972.
|
|
25
|
CLSI: Method for Antifungal Disk Diffusion
Susceptibility Testing of Nondermatophyte Filamentous Fungi.
Clinical and Laboratory Standards Institute, Wayne, PA, 2010.
|
|
26
|
Qiu Y, Zhou Y, Chang Y, Liang X, Zhang H,
Lin X, Qing K, Zhou X and Luo Z: The effects of ventilation,
humidity, and temperature on bacterial growth and bacterial genera
distribution. Int J Environ Res Public Health.
19(15345)2022.PubMed/NCBI View Article : Google Scholar
|
|
27
|
Buckley LB and Huey RB: How extreme
temperatures impact organisms and the evolution of their thermal
tolerance. Integr Comp Biol. 56:98–109. 2016.PubMed/NCBI View Article : Google Scholar
|
|
28
|
Donhauser J, Niklaus PA, Rousk J, Larose C
and Frey B: Temperatures beyond the community optimum promote the
dominance of heat-adapted, fast growing and stress resistant
bacteria in alpine soils. Soil Biol Biochem. 148(107873)2020.
|
|
29
|
Rodríguez-Verdugo A, Lozano-Huntelman N,
Cruz-Loya M, Savage V and Yeh P: Compounding effects of climate
warming and antibiotic resistance. IScience.
23(101024)2020.PubMed/NCBI View Article : Google Scholar
|
|
30
|
Nhu NT, Wang HJ and Dufour YS: Acidic pH
reduces Vibrio cholerae motility in mucus by weakening flagellar
motor torque. bioRxiv: Dec 10, 2019 (Epub ahead of print). doi:
https://doi.org/10.1101/871475.
|
|
31
|
Huq A, West PA, Small EB, Huq MI and
Colwell RR: Influence of water temperature, salinity, and pH on
survival and growth of toxigenic Vibrio cholerae serovar O1
associated with live copepods in laboratory microcosms. Appl
Environ Microbiol. 48:420–424. 1984.PubMed/NCBI View Article : Google Scholar
|
|
32
|
Nhu NTQ, Lee JS, Wang HJ and Dufour YS:
Alkaline pH increases swimming speed and facilitates mucus
penetration for Vibrio cholerae. J Bacteriol. 203:e00607–20.
2021.PubMed/NCBI View Article : Google Scholar
|
|
33
|
Kostiuk B, Becker ME, Churaman CN, Black
JJ, Payne SM, Pukatzki S and Koestler BJ: Vibrio cholerae alkalizes
its environment via citrate metabolism to inhibit enteric growth in
vitro. Microbiol Spectr. 11(e0491722)2023.PubMed/NCBI View Article : Google Scholar
|
|
34
|
McCarthy SA: Effects of temperature and
salinity on survival of toxigenic Vibrio cholerae O1 in seawater.
Microb Ecol. 31:167–175. 1996.PubMed/NCBI View Article : Google Scholar
|
|
35
|
Singleton FL, Attwell R, Jangi S and
Colwell RR: Effects of temperature and salinity on Vibrio cholerae
growth. Appl Environ Microbiol. 44:1047–1058. 1982.PubMed/NCBI View Article : Google Scholar
|
|
36
|
Montilla R, Chowdhury MA, Huq A, Xu B and
Colwell RR: Serogroup conversion of Vibrio cholerae non-O1 to
Vibrio cholerae O1: Effect of growth state of cells, temperature,
and salinity. Can J Microbiol. 42:87–93. 1996.PubMed/NCBI View Article : Google Scholar
|
|
37
|
Frith A, Hayes-Mims M, Carmichael R and
Björnsdóttir-Butler K: Effects of environmental and water quality
variables on histamine-producing bacteria concentration and species
in the northern Gulf of Mexico. Microbiol Spectr.
11(e0472022)2023.PubMed/NCBI View Article : Google Scholar
|
|
38
|
Yuan XH, Li YM, Vaziri AZ, Kaviar VH, Jin
Y, Jin Y, Maleki A, Omidi N and Kouhsari E: Global status of
antimicrobial resistance among environmental isolates of Vibrio
cholerae O1/O139: A systematic review and meta-analysis. Antimicrob
Resist Infect Control. 11(62)2022.PubMed/NCBI View Article : Google Scholar
|
|
39
|
Parvin I, Shahunja KM, Khan SH, Alam T,
Shahrin L, Ackhter MM, Sarmin M, Dash S, Rahman MW, Shahid AS, et
al: Changing susceptibility pattern of Vibrio cholerae O1 isolates
to commonly used antibiotics in the largest diarrheal disease
hospital in Bangladesh during 2000-2018. Am J Trop Med Hyg.
103:652–658. 2020.PubMed/NCBI View Article : Google Scholar
|
|
40
|
Cruz-Loya M, Kang TM, Lozano NA, Watanabe
R, Tekin E, Damoiseaux R, Savage VM and Yeh PJ: Stressor
interaction networks suggest antibiotic resistance co-opted from
stress responses to temperature. ISME J. 13:12–23. 2019.PubMed/NCBI View Article : Google Scholar
|
|
41
|
Thaotumpitak V, Sripradite J, Atwill ER
and Jeamsripong S: Emergence of colistin resistance and
characterization of antimicrobial resistance and virulence factors
of Aeromonas hydrophila, Salmonella spp., and Vibrio cholerae
isolated from hybrid red tilapia cage culture. PeerJ.
11(e14896)2023.PubMed/NCBI View Article : Google Scholar
|
|
42
|
Sharif N, Ahmed SN, Khandaker S, Monifa
NH, Abusharha A, Vargas DLR, Díez IT, Castilla AGK, Talukder AA,
Parvez AK and Dey SK: Multidrug resistance pattern and molecular
epidemiology of pathogens among children with diarrhea in
Bangladesh, 2019-2021. Sci Rep. 13(13975)2023.PubMed/NCBI View Article : Google Scholar
|
|
43
|
Das B, Verma J, Kumar P, Ghosh A and
Ramamurthy T: Antibiotic resistance in Vibrio cholerae:
Understanding the ecology of resistance genes and mechanisms.
Vaccine. 38 (Suppl 1):A83–A92. 2020.PubMed/NCBI View Article : Google Scholar
|
|
44
|
Luo XW, Liu PY, Miao QQ, Han RJ, Wu H, Liu
JH, He DD and Hu GZ: Multidrug resistance genes carried by a novel
transposon Tn 7376 and a genomic island named MMGI-4 in a
pathogenic morganella morganii isolate. Microbiology Spectrum.
10:e00265–22. 2022.PubMed/NCBI View Article : Google Scholar
|
|
45
|
Robbins N, Caplan T and Cowen LE:
Molecular evolution of antifungal drug resistance. Annu Rev
Microbiol. 71:753–775. 2017.PubMed/NCBI View Article : Google Scholar
|
|
46
|
Osset-Trénor P, Pascual-Ahuir A and Proft
M: Fungal drug response and antimicrobial resistance. J Fungi
(Basel). 9(565)2023.PubMed/NCBI View Article : Google Scholar
|
|
47
|
Sanglard D, Ischer F, Parkinson T,
Falconer D and Bille J: Candida albicans mutations in the
ergosterol biosynthetic pathway and resistance to several
antifungal agents. Antimicrob Agents Chemother. 47:2404–2412.
2003.PubMed/NCBI View Article : Google Scholar
|